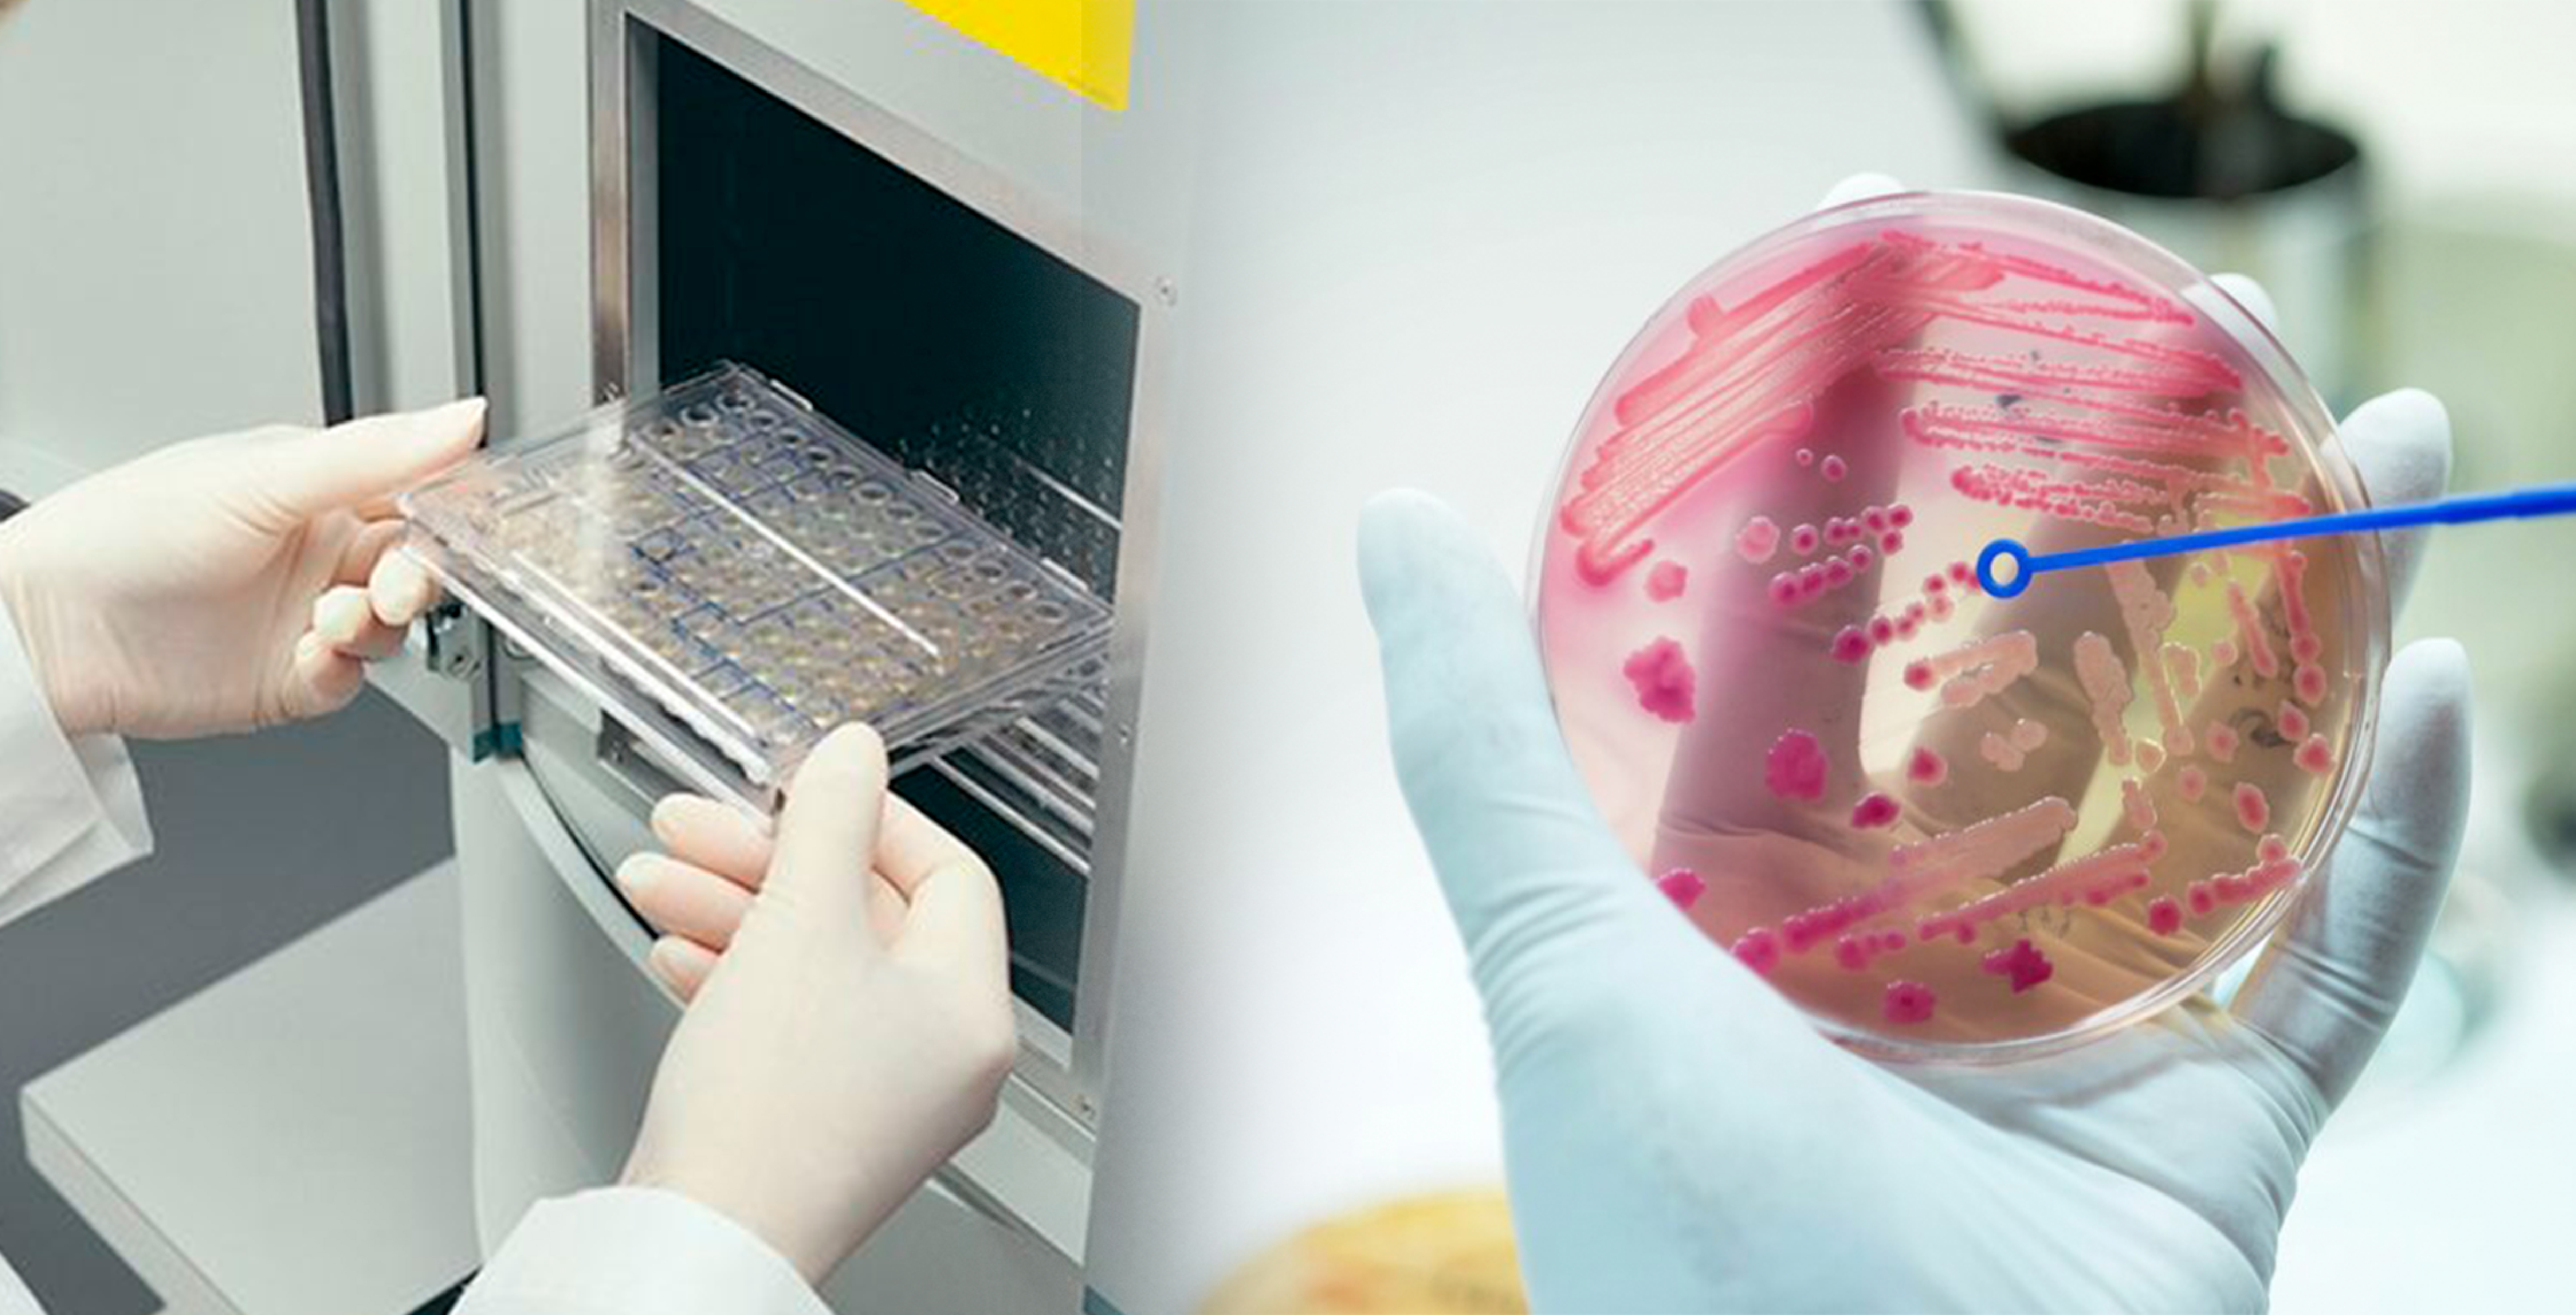
Reduce las limitaciones clínicamente significativa de cualquier sistema de ID/AST automatizado.

Sistemas de Microbiología ID/AST
Sistemas microbiológicos para identificación microbiana y susceptibilidad a los antimicrobianos de forma confiable y reproducible.
- Detección exacta de las enterobacterias resistentes a carbapenemasas que representan un riesgo para la salud.
- Detección avanzada de la resistencia emergente para agentes patógenos resistentes, incluidos ESBL, MRSA, VRSA, VISA y VRE 2.
- Reducción del tiempo de respuesta para paneles de ID rápida y de especialidad.
- Soluciones probadas a través de experiencia científica y formulaciones antibióticas patentadas.
- Cumplimiento con CFR 21 parte 11.

MicroScan
WalkAway plus
Optimiza los flujos de trabajo para pruebas de ID/AST gracias a la automatización inteligente.
Ver más...
- Permite el procesamiento simultáneo de paneles convencionales, rápidos y de especialidad de forma automática.
- Detección precisa de la resistencia emergente a los patógenos más resistentes, incluidos VISA, VRSA y MRSA2.
- Procesa los paneles de ID rápida y de especialidad para reducir el tiempo de respuesta.
- Compatible en modelos de capacidad de 40 y 96 paneles.
- Software personalizable que automatiza la detección de resultados atípicos para una rápida elaboración de informes.
- El software LabPro Connect le permite exportar los datos de múltiples sistemas de pruebas en informes de epidemiología.
- Volumen de dispensación de reactivo (μl): Entre 15 y 75, en función del reactivo dispensado.
- Volumen de dispensación de aceite (μl): Entre 60 y 150.

MicroScan
MicroScan WalkAway
Ofrece una detección fiable de resistencia a los antimicrobianos crítica y emergente para laboratorios.
Ver más...
- Datos de MIC y de susceptibilidad que se correlacionan con la microdilución en caldo clásica y la difusión en disco de manera confiable.
- Automatiza la detección de resultados atípicos para un reconocimiento e informes rápidos.
- Detección avanzada de resistencia emergente a patógenos difíciles, incluidos ESBL, MRSA, VRSA, VISA y VRE2.
- Compatible en modelos de capacidad de 40 y 96 paneles.
- Pruebas de ID/AST convencionales, pruebas de ID rápidas o especializadas simultáneamente sin sacrificar la precisión.
- El software LabPro Connect le permite exportar los datos de múltiples sistemas de pruebas en informes de epidemiología.
- Lectura automatizada que ofrece identificación y susceptibilidad bacteriana en segundos.
- Software personalizable que automatiza la detección de resultados atípicos para una rápida elaboración de informes.

MicroScan
autoSCAN-4
Proporciona pruebas simplificadas de ID/AST en un paquete altamente fiable y asequible.
Ver más...
- Sistema automatizado para la identificación y susceptibilidad de bacterias y/o levaduras presentes en muestras biológicas.
- El sistema autoSCAN-4 procesa paneles en cuestión de segundos, simplifica las pruebas de ID/AST y estandariza los resultados.
- El tipo de lectura es colorimétrica y/o fluorométrica.
- Permite la selección de los métodos de inoculación para adaptarse a los flujos de trabajo.
- Se puede confirmar de manera visual los resultados atípicos.
- El software procesa la información y valida la identificación y sensibilidad de los resultados.
Estamos listos para ayudarte
Contacta a uno de nuestros especialistas para recibir una asesoría personalizada sobre estos equipos o cotiza
INOLAB ESPECIALISTAS DE SERVICIO S.A. DE C.V.
Aniceto Ortega No.1341, Colonia del Valle, C.P. 03100, Ciudad de México.Ciudad de México
55 5524 2429
Guadalajara
33 3330 2848
Relacionados
Preguntas Frecuentes
- ¿Qué es el sistema MicroScan?
- El sistema MicroScan WalkAway de Beckman Coulter es una plataforma automatizada de microbiología clínica que identifica microorganismos y realiza pruebas de susceptibilidad antimicrobiana (AST) a partir de muestras clínicas, con resultados validados por CLSI y EUCAST.
- ¿Cuántos microorganismos puede identificar el MicroScan?
- El sistema identifica más de 700 especies de bacterias aerobias y anaerobias, incluyendo gram positivos, gram negativos, hongos y levaduras, utilizando paneles convencionales, rápidos o de caldo. La identificación se basa en pruebas bioquímicas miniaturizadas.
- ¿Qué es la prueba de susceptibilidad antimicrobiana (AST)?
- El AST determina la Concentración Mínima Inhibitoria (MIC) de múltiples antibióticos frente a un microorganismo aislado, permitiendo seleccionar el tratamiento antibiótico más eficaz. MicroScan reporta resultados categoriales (S/I/R) y CMI numéricas para cada antimicrobiano.
- ¿Cuál es el tiempo de resultado con MicroScan WalkAway?
- Los paneles convencionales entregan resultados en 15-18 horas. Los paneles rápidos permiten identificación y AST preliminar en 5-7 horas, adelantando la toma de decisiones clínicas en pacientes críticos.
- ¿Cómo se integra MicroScan con el sistema de información del laboratorio (LIS)?
- MicroScan cuenta con interfaz bidireccional HL7/ASTM para conectarse a cualquier LIS o HIS, permitiendo transmisión automática de resultados, trazabilidad de órdenes y generación de reportes epidemiológicos de resistencia antimicrobiana.